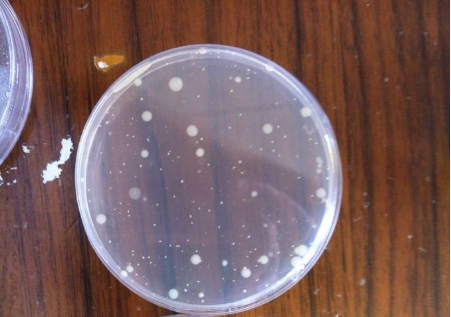
1747830117745547.png 微信截圖_20250521202133.png

微生物薄膜過濾法和平皿法是兩種常用的微生物檢測方法,廣泛應用于醫藥、食品、化妝品等行業的微生物限度檢查。二者在原理、操作流程、適用場景等方面存在明顯區別,從原理到實操:一文讀懂薄膜過濾法 vs 平皿法的適用邊界,以下是具體分析:
一、原理不同
1. 薄膜過濾法
2. 平皿法

二、操作流程不同
1. 薄膜過濾法
2. 平皿法(以傾注法為例)
三、適用場景不同
1. 薄膜過濾法
2. 平皿法
四、優缺點對比
| 維度 | 薄膜過濾法 | 平皿法 |
|---|---|---|
| 優點 | - 能有效去除抑菌成分,適用于復雜樣品 - 濃縮微生物,檢測靈敏度高 - 減少供試品本身顏色或雜質對結果的干擾 | - 操作簡單,無需復雜設備 - 適合大批量樣品快速檢測 - 固體樣品處理相對直接 |
| 缺點 | - 需要過濾裝置和濾膜,成本較高 - 操作步驟較多,耗時較長 - 固體樣品需先溶解處理 | - 無法去除抑菌成分,可能導致結果偏低 - 低微生物含量樣品易漏檢 - 培養基用量較大 |
五、注意事項
總結
實際檢測中,可能需結合供試品預試驗(如抑菌性檢查)來確定最佳方法,必要時可聯合使用兩種方法或采用其他驗證手段(如中和法)以確保結果準確。







 客服1
客服1